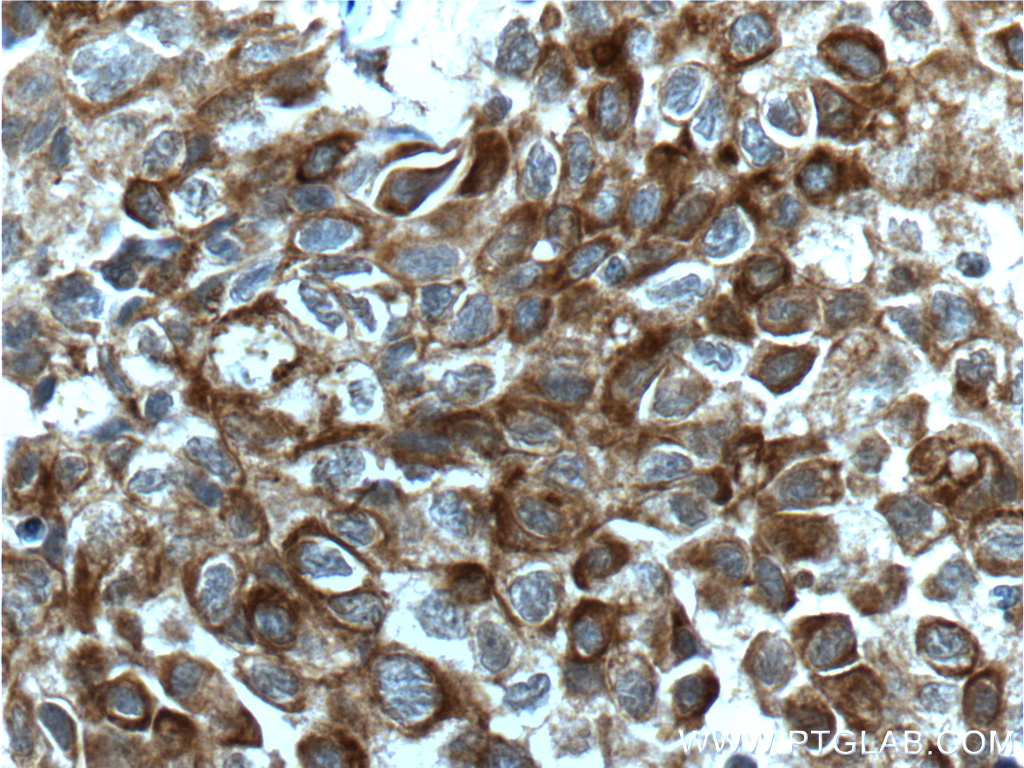

验证数据展示
经过测试的应用
| Positive WB detected in | A549 cells, Raji cells, Jurkat cells, rat brain tissue, HeLa cells, NIH/3T3 cells, human placenta tissue, C6 cells, K-562 cells, mouse placenta tissue, RAW264.7 |
| Positive IP detected in | k-562 cells |
| Positive IHC detected in | human lung cancer tissue, human colon tissue Note: suggested antigen retrieval with TE buffer pH 9.0; (*) Alternatively, antigen retrieval may be performed with citrate buffer pH 6.0 |
| Positive IF/ICC detected in | NIH/3T3 cells |
推荐稀释比
| 应用 | 推荐稀释比 |
|---|---|
| Western Blot (WB) | WB : 1:2000-1:12000 |
| Immunoprecipitation (IP) | IP : 0.5-4.0 ug for 1.0-3.0 mg of total protein lysate |
| Immunohistochemistry (IHC) | IHC : 1:50-1:500 |
| Immunofluorescence (IF)/ICC | IF/ICC : 1:200-1:800 |
| It is recommended that this reagent should be titrated in each testing system to obtain optimal results. | |
| Sample-dependent, Check data in validation data gallery. | |
产品信息
10783-1-AP targets BCL2L1 in WB, IHC, IF/ICC, IP, ChIP, ELISA applications and shows reactivity with human, mouse, rat samples.
| 经测试应用 | WB, IHC, IF/ICC, IP, ELISA Application Description |
| 文献引用应用 | WB, IHC, IF, IP, ChIP |
| 经测试反应性 | human, mouse, rat |
| 文献引用反应性 | human, mouse, rat, pig, canine, zebrafish, hamster, sheep, goat |
| 免疫原 |
CatNo: Ag1232 Product name: Recombinant human Bcl-xL protein Source: e coli.-derived, PGEX-4T Tag: GST Domain: 1-233 aa of BC019307 Sequence: MSQSNRELVVDFLSYKLSQKGYSWSQFSDVEENRTEAPEGTESEMETPSAINGNPSWHLADSPAVNGATGHSSSLDAREVIPMAAVKQALREAGDEFELRYRRAFSDLTSQLHITPGTAYQSFEQVVNELFRDGVNWGRIVAFFSFGGALCVESVDKEMQVLVSRIAAWMATYLNDHLEPWIQENGGWDTFVELYGNNAAAESRKGQERFNRWFLTGMTVAGVVLLGSLFSRK 种属同源性预测 |
| 宿主/亚型 | Rabbit / IgG |
| 抗体类别 | Polyclonal |
| 产品类型 | Antibody |
| 全称 | BCL2-like 1 |
| 别名 | Bcl-xL, Apoptosis regulator Bcl X, Apoptosis regulator Bcl-X, Bcl2-L-1, Bcl-2-like protein 1 |
| 计算分子量 | 26 kDa |
| 观测分子量 | 30 kDa |
| GenBank蛋白编号 | BC019307 |
| 基因名称 | BCL2L1 |
| Gene ID (NCBI) | 598 |
| RRID | AB_2064724 |
| 偶联类型 | Unconjugated |
| 形式 | Liquid |
| 纯化方式 | Antigen affinity purification |
| UNIPROT ID | Q07817 |
| 储存缓冲液 | PBS with 0.02% sodium azide and 50% glycerol, pH 7.3. |
| 储存条件 | Store at -20°C. Stable for one year after shipment. Aliquoting is unnecessary for -20oC storage. |
背景介绍
BCL2L1 is a member of the BCL-2 protein family. BCL2L1 is expressed as three isoforms, Bcl-X(L), Bcl-X(s), and Bcl-X(beta), and is located at the outer mitochondrial membrane. The Bcl-X(L) isoform is a 233 amino acid protein, acting as an apoptotic inhibitor. Bcl-XL can form heterodimers with BAX, BAK, or BCL2, and the heterodimerization with BAX does not seem to be required for anti-apoptotic activity. The Bcl-X(s) isoform is a shorter variant that is 178 amino acids in length and lacks a 63 amino acid region (amino acids 126-188), acting as an apoptotic activator. Bcl-X(beta) is a 227 amino acid protein. This antibody can recognize Bcl-XL, Bcl-X(s) and Bcl-X(Beta).
实验方案
| Product Specific Protocols | |
|---|---|
| IF protocol for BCL2L1 antibody 10783-1-AP | Download protocol |
| IHC protocol for BCL2L1 antibody 10783-1-AP | Download protocol |
| IP protocol for BCL2L1 antibody 10783-1-AP | Download protocol |
| WB protocol for BCL2L1 antibody 10783-1-AP | Download protocol |
| Standard Protocols | |
|---|---|
| Click here to view our Standard Protocols |
发表文章
| Species | Application | Title |
|---|---|---|
Immunity cis-B7:CD28 interactions at invaginated synaptic membranes provide CD28 co-stimulation and promote CD8+ T cell function and anti-tumor immunity | ||
Nat Commun Structural and functional analyses of hepatitis B virus X protein BH3-like domain and Bcl-xL interaction. | ||
Carbohydr Polym A multi-bioresponsive self-assembled nano drug delivery system based on hyaluronic acid and geraniol against liver cancer | ||
Adv Healthc Mater Copper-Based Composites Nanoparticles Improve Triple-Negative Breast Cancer Treatment with Induction of Apoptosis-Cuproptosis and Immune Activation | ||
Cancer Res Bcl-xL enforces a slow-cycling state necessary for survival in the nutrient-deprived microenvironment of pancreatic cancer. | ||
Phytomedicine LC-MS based metabonomics study on protective mechanism of ESWW in cerebral ischemia via CYTC/Apaf-1/NDRG4 pathway |